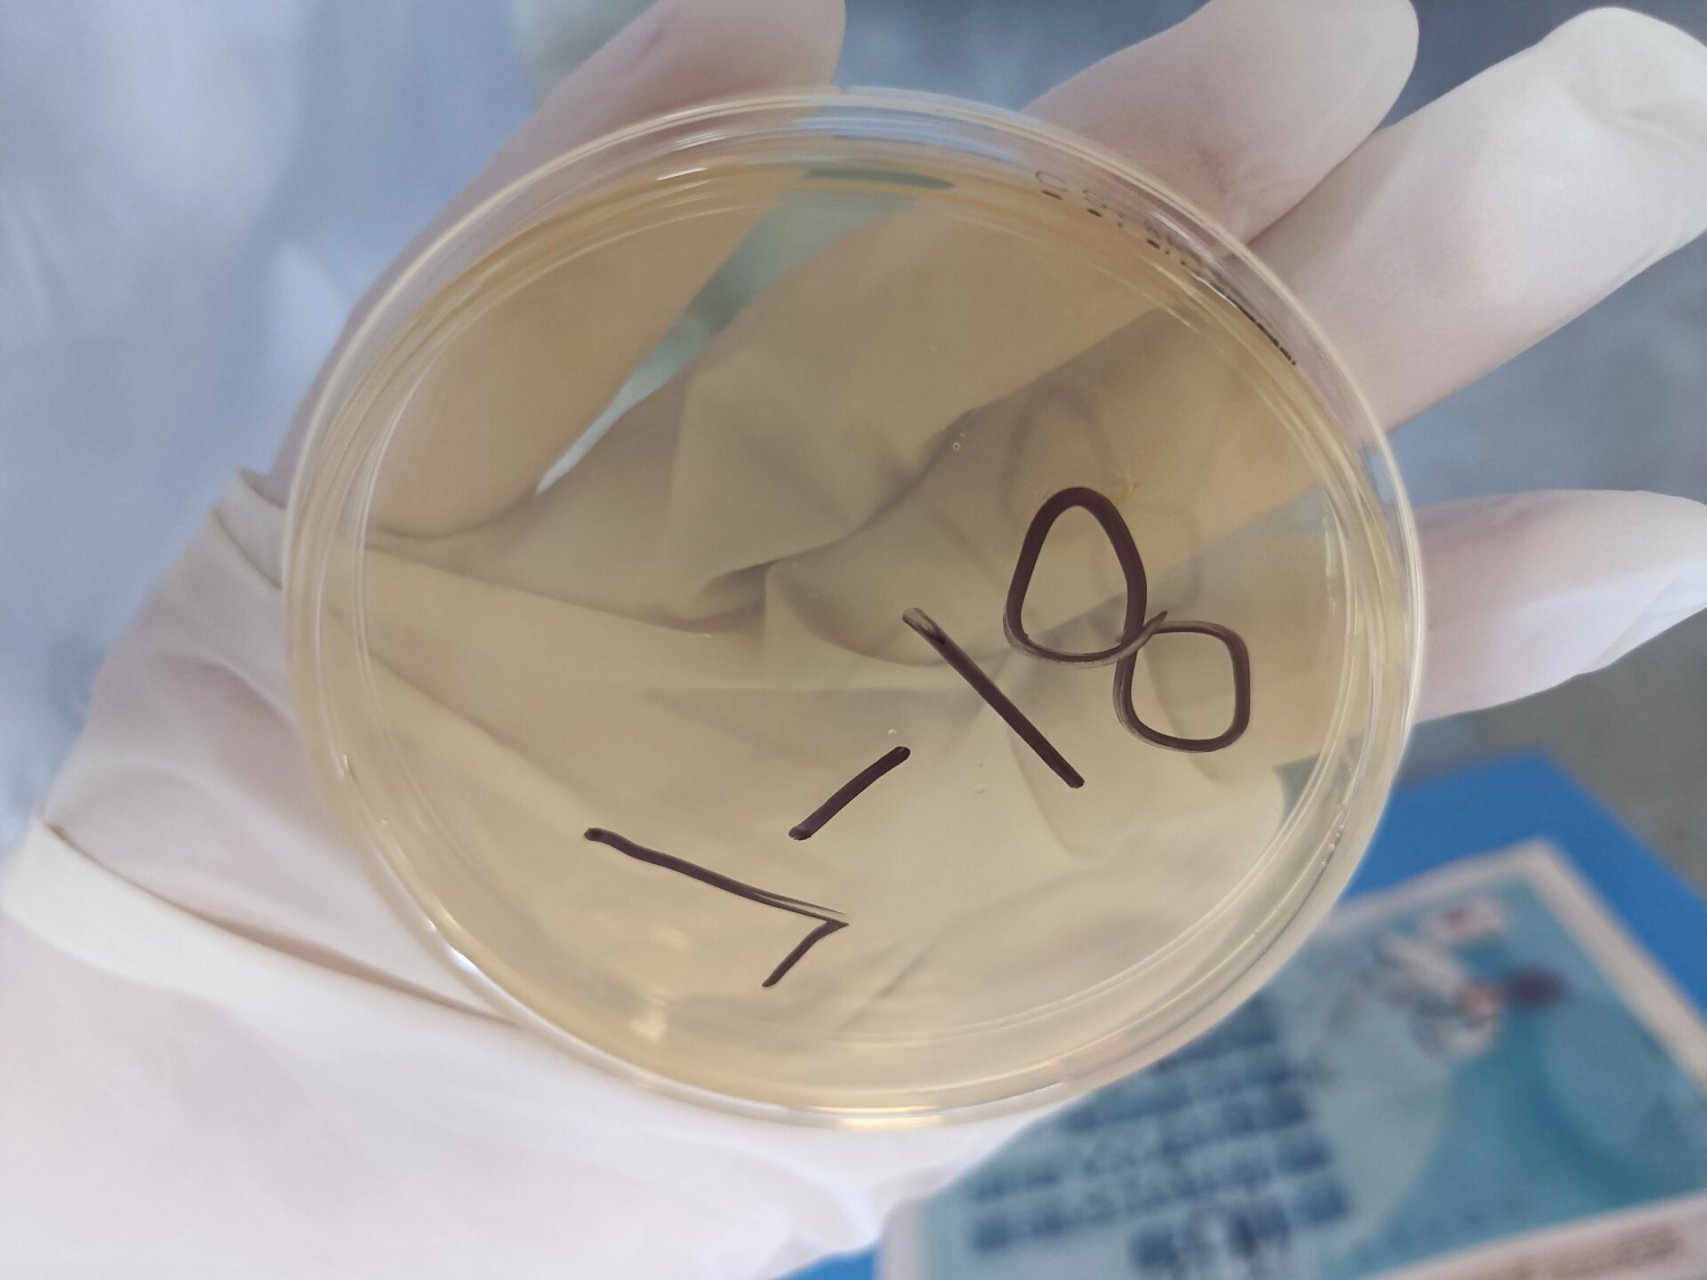
实验课之细菌平板划线分离培养法 周一做的实验,好玩的捏,第一区划得
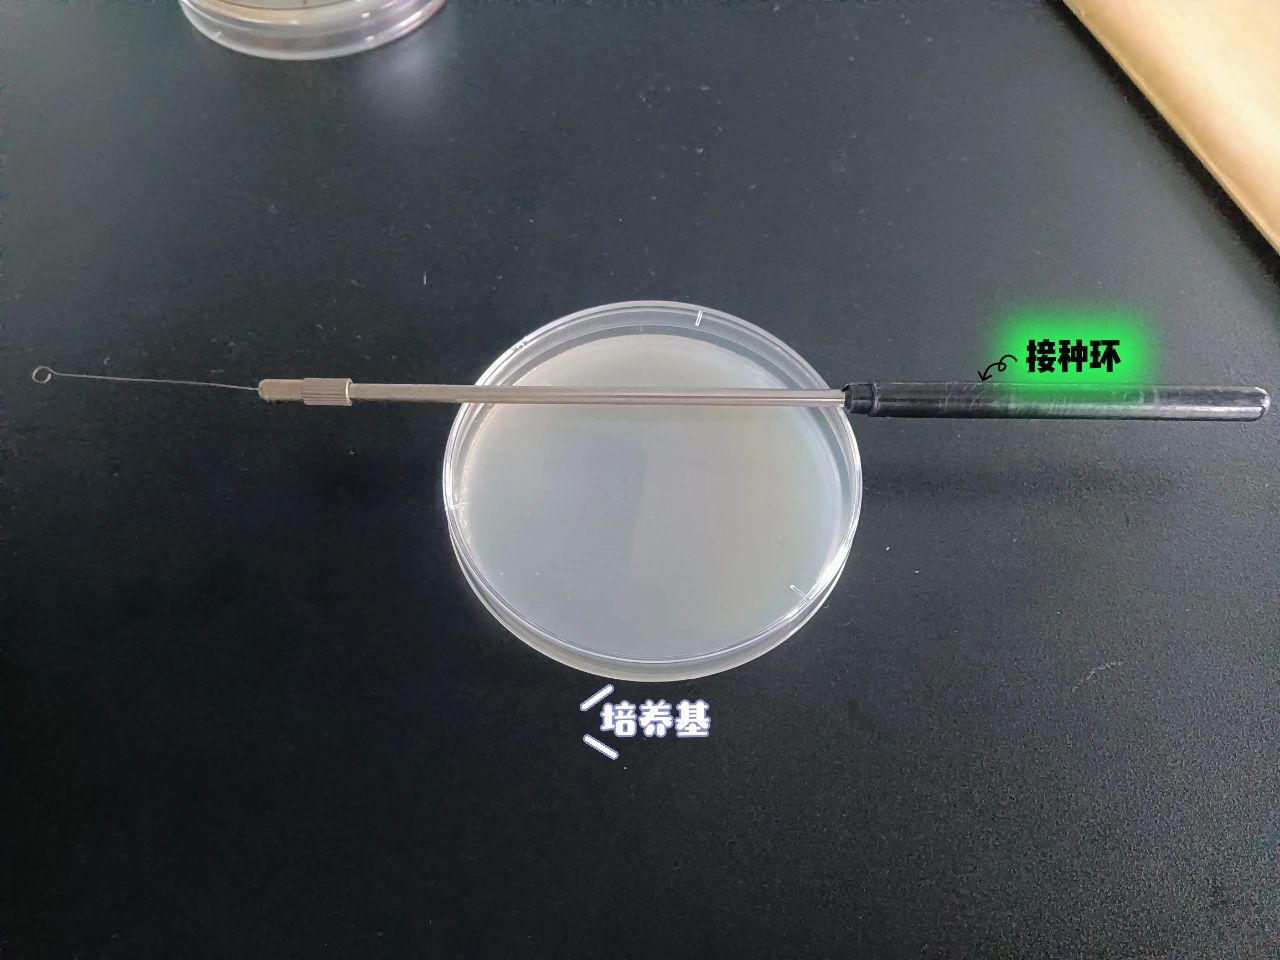
实验四:细菌的划线分离与培养
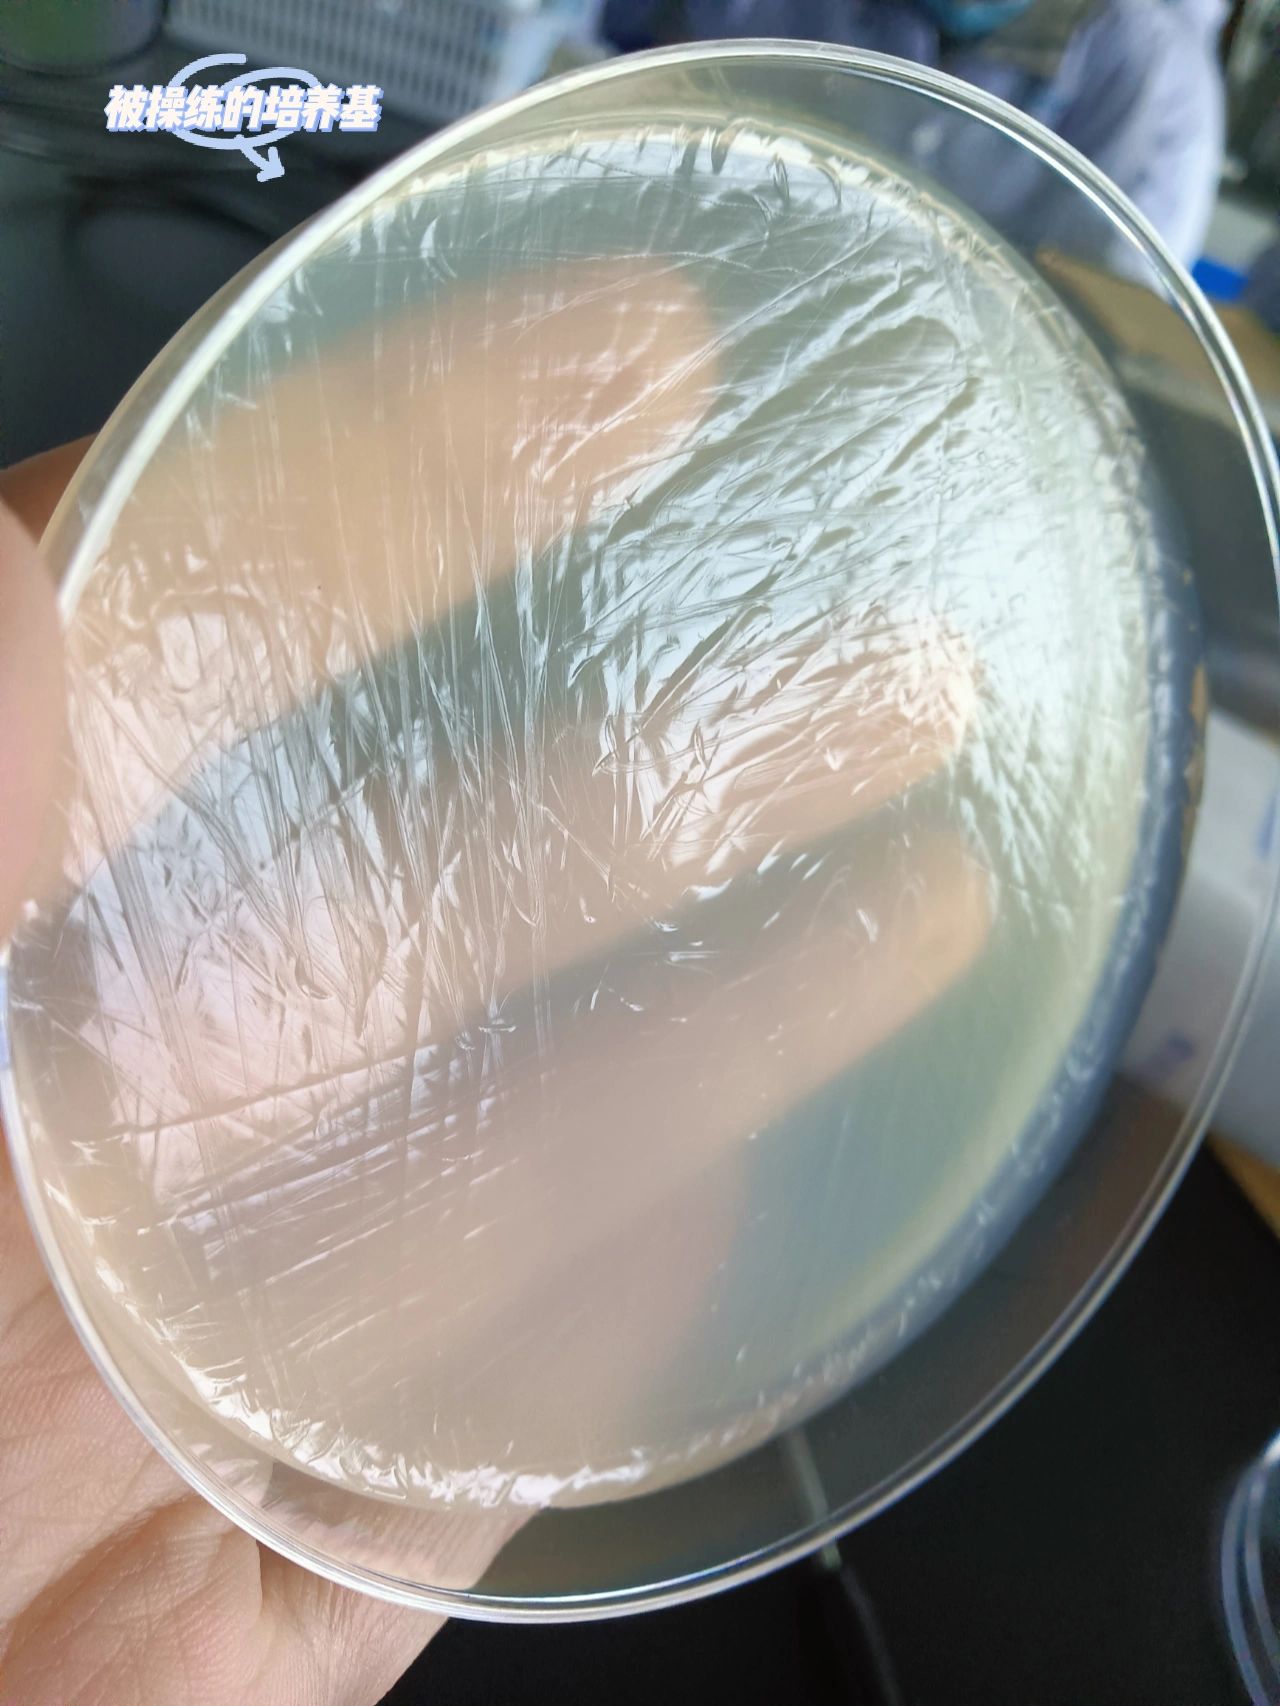
实验四:细菌的划线分离与培养

细菌划线分离

细菌划线分离与纯培养ppt模板
图片尺寸1200x5391
实验课之细菌平板划线分离培养法 周一做的实验,好玩的捏,第一区划得
图片尺寸960x1280
细菌的分离培养及移植
图片尺寸830x689
如何分区划线画的好 今天我们说一下细菌分离画线,其实画线的目标是
图片尺寸1706x1280
实验课之细菌平板划线分离培养法 周一做的实验,好玩的捏,第一区划得
图片尺寸1707x1280
平板划线分离法,微生物,培养基,细菌接种,污染,微生物群,第1张
图片尺寸907x491
菌落划线分离练习
图片尺寸1080x1440
细菌的平板划线分离法
图片尺寸1440x900
实验四:细菌的划线分离与培养
图片尺寸1280x960
实验四:细菌的划线分离与培养
图片尺寸1280x1706
如何利用lb平板进行划线及分离细菌_实验_菌落_接种
图片尺寸504x250
细菌平板划线分离培养法实验(2)
图片尺寸640x312
细菌检测最基础的三区划线,你学会了吗?
图片尺寸1080x509
细菌的分离培养
图片尺寸1015x450
菌种平板划线——三区分离法 .
图片尺寸386x387
我的大肠杆菌划线分离
图片尺寸1080x810
细菌的平板划线分离法
图片尺寸672x378
细菌的接种与分离培养
图片尺寸725x386
细菌纯种分离的操作方法
图片尺寸1579x675
细菌的分离培养
图片尺寸673x372